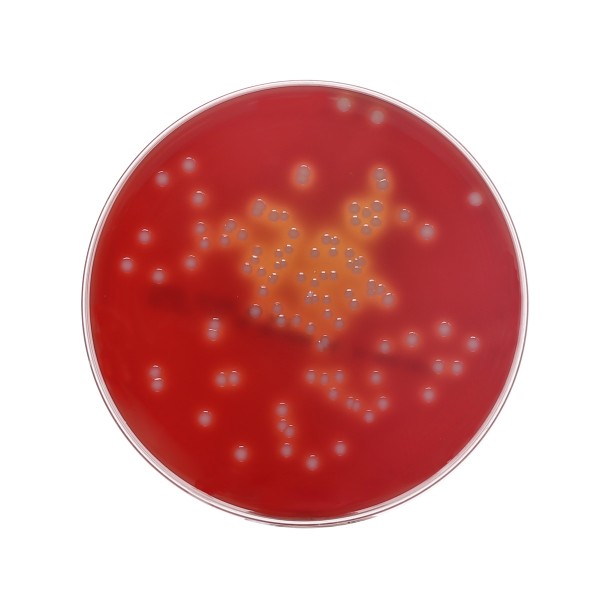
Schafblutagarplatte

Cookie-Einstellungen
Diese Website benutzt Cookies, die für den technischen Betrieb der Website erforderlich sind und stets gesetzt werden. Andere Cookies, die den Komfort bei Benutzung dieser Website erhöhen, der Direktwerbung dienen oder die Interaktion mit anderen Websites und sozialen Netzwerken vereinfachen sollen, werden nur mit Ihrer Zustimmung gesetzt.
Konfiguration
Technisch erforderlich
Diese Cookies sind für die Grundfunktionen des Shops notwendig.
"Alle Cookies ablehnen" Cookie
"Alle Cookies annehmen" Cookie
Advanced Cart
Affiliate-Code
Ausgewählter Shop
CSRF-Token
Cookie-Einstellungen
Individuelle Preise
Kunden-Wiedererkennung
Kundenspezifisches Caching
PayPal-Zahlungen
Session
Währungswechsel
Komfortfunktionen
Diese Cookies werden genutzt um das Einkaufserlebnis noch ansprechender zu gestalten, beispielsweise für die Wiedererkennung des Besuchers.
Wunschliste
Statistik & Tracking
Endgeräteerkennung
Partnerprogramm
Der Artikel wurde erfolgreich hinzugefügt.
- Artikel-Nr.: 7812166
- Hersteller-Artikel-Nr.: MP130120PT
Dieses Medium wird zur Kultivierung anspruchsvoller Organismen und zur Untersuchung... mehr
Dieses Medium wird zur Kultivierung anspruchsvoller Organismen und zur Untersuchung hämolytischer Reaktionen empfohlen. Schafblutagar wurde so formuliert, dass es mit Schafblut kompatibel ist und verbesserte hämolytische Reaktionen der Organismen ermöglicht. Trypton, Pepton und Hefeextrakt liefern Stickstoff, Kohlenstoff, Aminosäuren und Vitamine. Natriumchlorid erhält das osmotische Gleichgewicht.
Weiterführende Links zu "Schafblutagarplatte"
Verfügbare Downloads:
Bewertungen lesen, schreiben und diskutieren... mehr
Kundenbewertungen für "Schafblutagarplatte"
Bewertung schreiben
Bewertungen werden nach Überprüfung freigeschaltet.